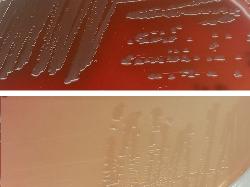

|
| Pseudomonas fluorescens |
Taxonomy
Morphology
Cultural characteristics
Biochemical characters
Ecology
Pathogenicity
References
Phylum Pseudomonadota (Proteobacteria), Class Gammaproteobacteria, Order Pseudomonadales, Family Pseudomonadaceae,
Genus Pseudomonas, Pseudomonas fluorescens Migula 1895.
Synonyms: Bacillus fluorescens liquefaciens Flügge 1886; Bacillus fluorescens Trevisan 1889; Bacterium fluorescens Lehmann and
Neumann 1896; Liquidomonas fluorescens Orla-Jensen 1909.
P. fluorescens biotypes according to Stanier et al. (1966):
Biotype A (I) - typical P. fluorescens *
Biotype B (II) - P. marginalis**, P. tolaasii
Biotype C (III)
Biotype D - P. chlororaphis
Biotype E - P. aureofaciens
Biotype F (IV) - P. lemmonieri
Biotype G - miscelanous strains (P. geniculata - incertae sedis)
*P. salomonii and P. palleroniana are closely related to biotype A.
** Strains of P. marginalis species have been included in biovar II of P. fluorescens.
Young et al. (1978) divided into three pathovars: P. marginalis pv. marginalis, P.
marginalis pv. alfalfa Shinde and Lukezic 1974b, associated with discolored alfalfa &
P. marginalis pv. pastinacae, pathogen of cultivated parsnip (Pastinaca sativa).
Genus Pseudomonas, Pseudomonas fluorescens Migula 1895.
Synonyms: Bacillus fluorescens liquefaciens Flügge 1886; Bacillus fluorescens Trevisan 1889; Bacterium fluorescens Lehmann and
Neumann 1896; Liquidomonas fluorescens Orla-Jensen 1909.
P. fluorescens biotypes according to Stanier et al. (1966):
Biotype A (I) - typical P. fluorescens *
Biotype B (II) - P. marginalis**, P. tolaasii
Biotype C (III)
Biotype D - P. chlororaphis
Biotype E - P. aureofaciens
Biotype F (IV) - P. lemmonieri
Biotype G - miscelanous strains (P. geniculata - incertae sedis)
*P. salomonii and P. palleroniana are closely related to biotype A.
** Strains of P. marginalis species have been included in biovar II of P. fluorescens.
Young et al. (1978) divided into three pathovars: P. marginalis pv. marginalis, P.
marginalis pv. alfalfa Shinde and Lukezic 1974b, associated with discolored alfalfa &
P. marginalis pv. pastinacae, pathogen of cultivated parsnip (Pastinaca sativa).
Gram-negative, 0.7-0.8 x 2.3-2.8 μm, motile by polar flagella, rods.
Cultures produce diffusible fluorescent pigments, particularly in iron-deficient media.
Blue, nondiffusible is pigment produced by some strains.
Strictly aerobic except from strains capable of denitrification (biotypes II, III and IV),
optimal temperature 28-30 ºC. Grows at 4 ºC, not at 41 ºC. Members of the biotypes I
and II are capable to adapt and survive at human body temperature (6).
Organic growth factors not required. Media: Nutritive agar, Trypticase Soy Agar, Mac
Conkey agar, King’s medium B agar.
Blue, nondiffusible is pigment produced by some strains.
Strictly aerobic except from strains capable of denitrification (biotypes II, III and IV),
optimal temperature 28-30 ºC. Grows at 4 ºC, not at 41 ºC. Members of the biotypes I
and II are capable to adapt and survive at human body temperature (6).
Organic growth factors not required. Media: Nutritive agar, Trypticase Soy Agar, Mac
Conkey agar, King’s medium B agar.
Isolated from oil, water, rarely from clinical samples (animal and human) and food
samples (cheese, meat, fish, raw milk).
P. salomonii was isolated from plants (lettuce, garlic, onion, rice).
samples (cheese, meat, fish, raw milk).
P. salomonii was isolated from plants (lettuce, garlic, onion, rice).
P. fluorescens is usually non-pathogenic but has been associated with food spoilage.
One report of human bacteremia. Saprophytic or opportunistic animal pathogen.
Possible fin rot in fish.
Used in depollution activities.
Some activity in inhibition of plant pathogens.
P. salomonii is pathogenic for garlic (Allium sativum).
One report of human bacteremia. Saprophytic or opportunistic animal pathogen.
Possible fin rot in fish.
Used in depollution activities.
Some activity in inhibition of plant pathogens.
P. salomonii is pathogenic for garlic (Allium sativum).
- Bergey’s Manual of Determinative Bacteriology, 9th ed., 1994.
- Yong-Ki Kim, Seung-Don Lee, Chung-Sik Choi, Sang-Bum Lee and Sang-Yeob Lee: Soft Rot of Onion Bulbs Caused by
Pseudomonas marginalis Under Low Temperature Storage. Plant Pathol. J. 18(4) : 199-203 (2002). - Louis Gardan, Patrizia Bella, Jean-Marie Meyer, Richard Christen, Philippe Rott, Wafa Achouak and Regine Samson:
Pseudomonas salomonii sp. nov., pathogenic on garlic, and Pseudomonas palleroniana sp. nov., isolated from rice. International
Journal of Systematic and Evolutionary Microbiology (2002), 52, 2065–2074. - George M. Garrity, Julia A. Bell & Timothy Lilburn: Order IX Pseudomonadales Orla-Jensen 1921 In: Bergey’s Manual of
Systematic Bacteriology, Second edition,Vol two, part B, George M. Garrity (Editor-in-Chief), 2005, pp. 323-442. - A. Chapalain, G. Rossignol, O. Lesouhaitier, A. Merieau, C. Gruffaz, J. Guerillon, J.-M. Meyer, N. Orange, and M.G.J. Feuilloley.
Comparative study of 7 fluorescent pseudomonad clinical isolates. Can. J. Microbiol. 54(1): 19–27 (2008). - Gennari, M., & Dragotto, F. (1992). A study of the incidence of different fluorescent Pseudomonas species and biovars in the
microflora of fresh and spoiled meat and fish, raw milk, cheese, soil and water. Journal of Applied Bacteriology, 72(4), 281–288.
doi:10.1111/j.1365-2672.1992.tb01836.x - N. H. Martin , S. C. Murphy , R. D. Ralyea , M. Wiedmann , and K. J. Boor 2011. When cheese gets the blues: Pseudomonas
fluorescens as the causative agent of cheese spoilage. J. Dairy Sci. 94 :3176–3183 doi: 10.3168/jds.2011-4312
All biovars are positive for catalase, oxidase, utilization of: acetate, L-alanine,
aminobutyrate, L-asparagine, L-aspartate, betaine, caprate, caprylate, citrate,
fumarate, L-glutamate, glutarate, glycerol, heptanoate, beta-hydroxybutyrate,
DL-lactate, L-malate, pelargonatee, L-proline, putrescine, pyruvate, succinate,
L-histidine, L-valine and beta-alanine.
All biovars are negative for beta-galactosidase, H2S production, indole production,
lysine decarboxylase, ornithine decarboxylase, urease, utilization of: acetamide,
mandelate, naphthalene, testosterone, D-tryptophan, cellobiose, ethylene glycole,
D-fucose, inulin, isopropanole, lactose, maleate, maltose, methanole, oxalate,
phthalate, poly-beta-hydroxybutyrate, salicin, starch, L-tryptophan and L-threonine.
P. salomonii can be differentiated from P. palleroniana by positive sucrose and
L-arabinose tests.
aminobutyrate, L-asparagine, L-aspartate, betaine, caprate, caprylate, citrate,
fumarate, L-glutamate, glutarate, glycerol, heptanoate, beta-hydroxybutyrate,
DL-lactate, L-malate, pelargonatee, L-proline, putrescine, pyruvate, succinate,
L-histidine, L-valine and beta-alanine.
All biovars are negative for beta-galactosidase, H2S production, indole production,
lysine decarboxylase, ornithine decarboxylase, urease, utilization of: acetamide,
mandelate, naphthalene, testosterone, D-tryptophan, cellobiose, ethylene glycole,
D-fucose, inulin, isopropanole, lactose, maleate, maltose, methanole, oxalate,
phthalate, poly-beta-hydroxybutyrate, salicin, starch, L-tryptophan and L-threonine.
P. salomonii can be differentiated from P. palleroniana by positive sucrose and
L-arabinose tests.

(c) Costin Stoica

| Antibiogram |
| Encyclopedia |
| Culture media |
| Biochemical tests |
| Stainings |
| Images |
| Movies |
| Articles |
| Identification |
| Software |
| R E G N U M PROKARYOTAE |
|
| Pseudomonas fluorescens, Gram stain |
| P. fluorescens colonies on Sheep Blood Agar (up) and MacConkey agar (down) |


| Back |